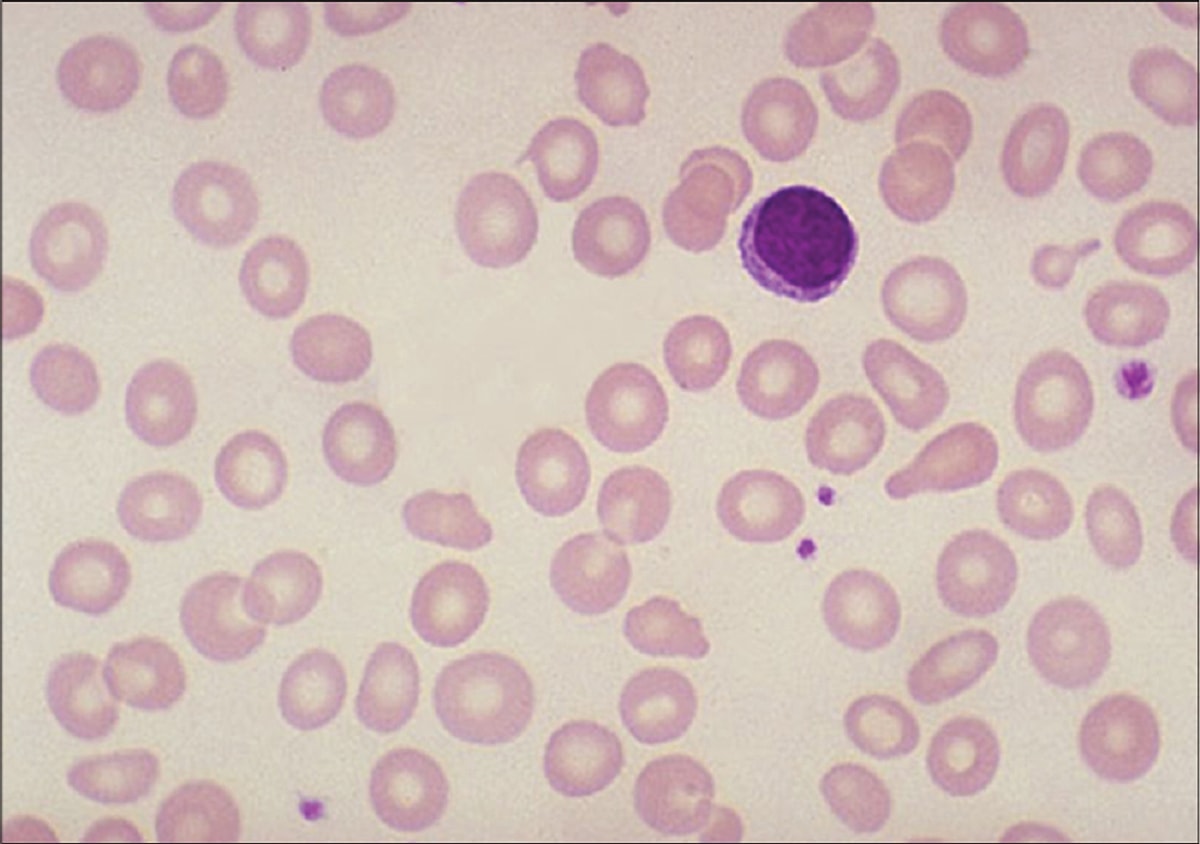

Микроциты макроциты
Эллинизм философия стоики эпикурейцы
Безударные падежные окончания е и
Что значит нептун в натальной карте
Каково значение культуры халифата история 6 класс
Допишите уравнение реакции разложения оксида
Поле чудес 14.02 2025
Deerma dem vx96w отзывы
Блендер ergolux
Как получить бесплатную машину в фортнайт
Желобок с шариком
Стд н
15 16 глава отцы и дети
Вставьте где необходимо согласные доблестный
Микроциты макроциты 111 фото